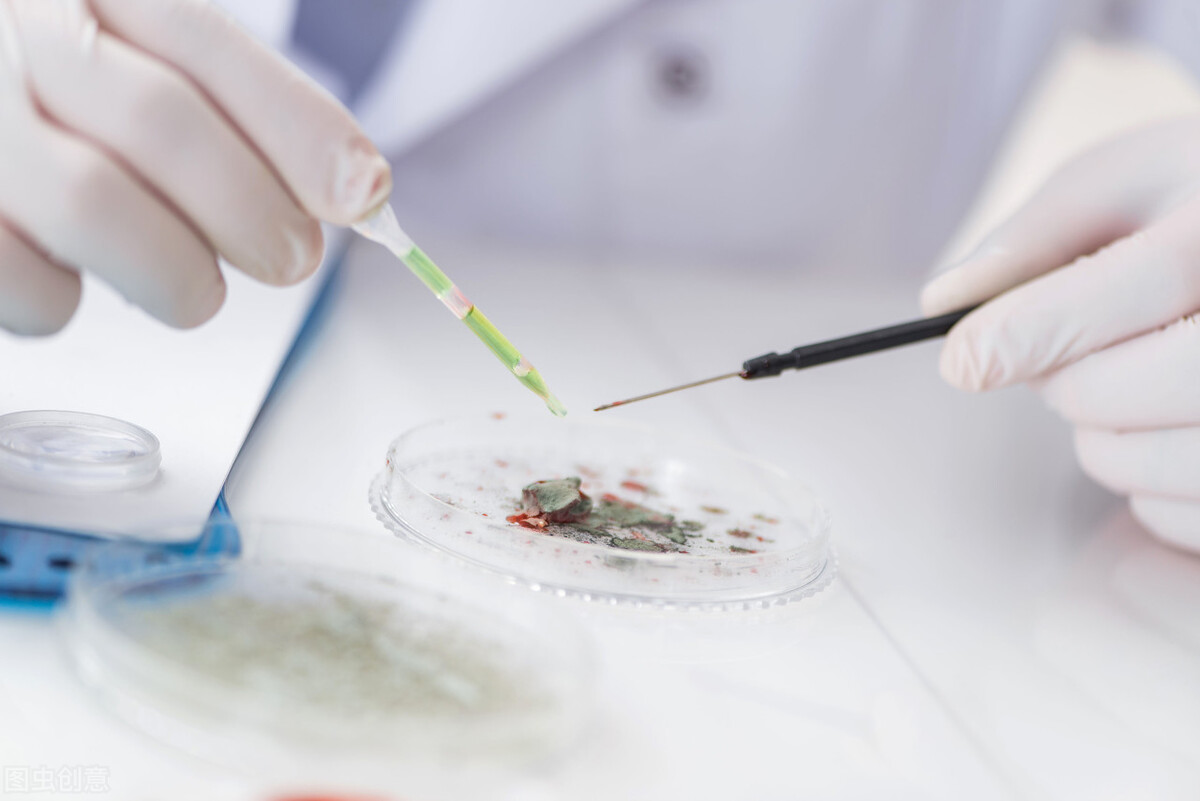
免疫治疗胶质瘤最新进展,胶质瘤能用靶向药物治疗吗

源自神经上皮的肿瘤统称为脑胶质瘤,占颅脑肿瘤的40%~50%,是最常见的原发性颅内肿瘤。年发病率为3~8人/10万人口。
今天咱们来了解一下胶质瘤的免疫治疗与精准靶向治疗的最新进展。
CDK4/6M制剂联合ERK1/2*制剂抑**在复发胶质母细胞瘤中的0期触发试验
过去50年,仅22项研究在胶质母细胞瘤(GBM)中探索了药效动力学和/或药代动力学,0期研究在GBM中明显未得到充分利用。
虽然CDK4/6*制剂抑**在Rb基因完好的肿瘤细胞中可破坏细胞周期中的G1期,但已有研究表明CDK4/6*制剂抑**单药治疗复发、Rb基因完好的GBM的疗效并不理想。因此,CDK4/6*制剂抑**单药不适用于复发GBM。
研究发现,CDK4/6*制剂抑**能够上调复发GBM中的ERK1/2。

研究招募了24名计划再手术的复发、经过STUPP方案治疗的GBM患者,患者的增强肿瘤病灶>1cm3,活检组织满足3个标准:1)Rb基因存在表达且无RB基因突变;2)CDKN2A/B/C缺失或CDK4/6扩增;3)PERK表达。
0期试验中,患者在第1至6天接受150mg的Abemaciclib(CDK4/6*制剂抑**)+200mg的LY3214996(ERK1/2*制剂抑**)治疗,在第6天进行手术,第一组患者在给药后7-9小时手术,第二组患者在给药后3-5小时手术。
安全性方面,70.8%的患者出现不良事件(AE),33.3%的患者出现≥3级不良事件,20.8%的患者出现严重不良事件,没有患者因为不良事件导致剂量中断或减量,有1名患者因为不良事件退出研究。
II期试验招募了16名患者,患者接受150mg的Abemaciclib+200mg的LY3214996治疗,直到疾病进展。如果16例受试者中有2例的PFS>6个月,则研究人数扩大到25,研究的中位无进展生存期(PFS)为2.4个月。

研究初步得出结论,虽然LY3214996效果有限,但Abemaciclib(CDK4/6*制剂抑**)与LY3214996(ERK1/2*制剂抑**)在非增强性GBM中达到了药理要求的浓度。
基于3名患者治疗前的活检,1名患者的LY3214996的暴露量与ERK1 /2通路抑制有关。
截止目前数据,在PK触发的II阶段患者中,两药联合的中位PFS与瑞博西尼药相媲美。
CTLA-4单抗联合PD-1单抗在复发胶质母细胞瘤中颅内注射的I期研究
CheckMate-143 III期研究显示Nivolumab单药并未改善复发GBM的总生存,ORR为7.8%;12个月总生存率为41%。
研究的主要终点为安全性/可行性。所有患者都接受了计划的术前10mg IV NIVO,所有患者都接受了计划的神经外科手术和研究药物的围手术期给药。

研究未有4-5级AE以及可疑的非预期严重不良反应(SUSARs)。未有患者由于irAE需要皮质类固醇(或其他免疫*制剂抑**)治疗。

研究的初步结果表明,颅内注射IPI和NIVO是可行的,且安全性可接受,免疫相关的非预期严重不良事件发生率低,且大部分不良事件都是低级别,NIVO在CSV内清除出乎意料地快。
OS的潜在有益影响似乎仅限于可切除的患者,怀疑CNS肿瘤负荷决定治疗结果(类似黑色素瘤脑转移),没有强有力的迹象表明围术期注射IPI/NIVO后,重复腔内给药NIVO会带来额外好处。
预测/预后组织生物标志物(包括B7-H3)有潜力指导合适患者筛选,CSV中存在淋巴细胞肿瘤抗原特异性。
正在进一步研究颅内IPI/NIVO给药设计,以作为新免疫组合治疗方案的基础。

Sorcin的上调将通过激活PI3K/AKT/mTOR通路促进胶质母细胞瘤进展
Sorcin(SRI)是一种可溶性钙(Ca2+)结合蛋白,是penta-EF-hand(PEF)蛋白质家族的重要成员,并参与了肿瘤发生。
在Oncomine和TCGA数据库中检查SRI在GBM中的表达,并通过免疫组织化学染色、western blot和RT-PCR在临床组织和细胞系中进一步测量。在体外模型中研究了SRI在GBM中的生物学功能,并进一步研究了潜在分子机制。
研究得出结论:
基于各种数据库,SRI在胶质母细胞瘤(GBM)中表达增加。

SRI对体外GBM产生影响。

体外模型发现SRI过表达促进GBM迁移和侵袭。

GBM细胞中的EM顶象和P13K/AKT/mT0R通路通过加强SRI表达而增强。

总的来说,上述发现表明SRI在GBM中表达上调,并通过触发PI3K/AKT/mTOR通路促进GBM进展。
结论
综上,在PK触发的I阶段患者中,CDK4/6*制剂抑**联合ERK1/2*制剂抑**联合的中位PFS与瑞博西尼(CDK4/6*制剂抑**)单药相媲美。
颅内注射IPI和NIVO是可行的,且安全性可接受,OS的潜在有益影响似乎仅限于可切除的患者。
SRI在GBM中表达上调,并通过触发PI3K/AKT/mTOR通路促进GBM进展。